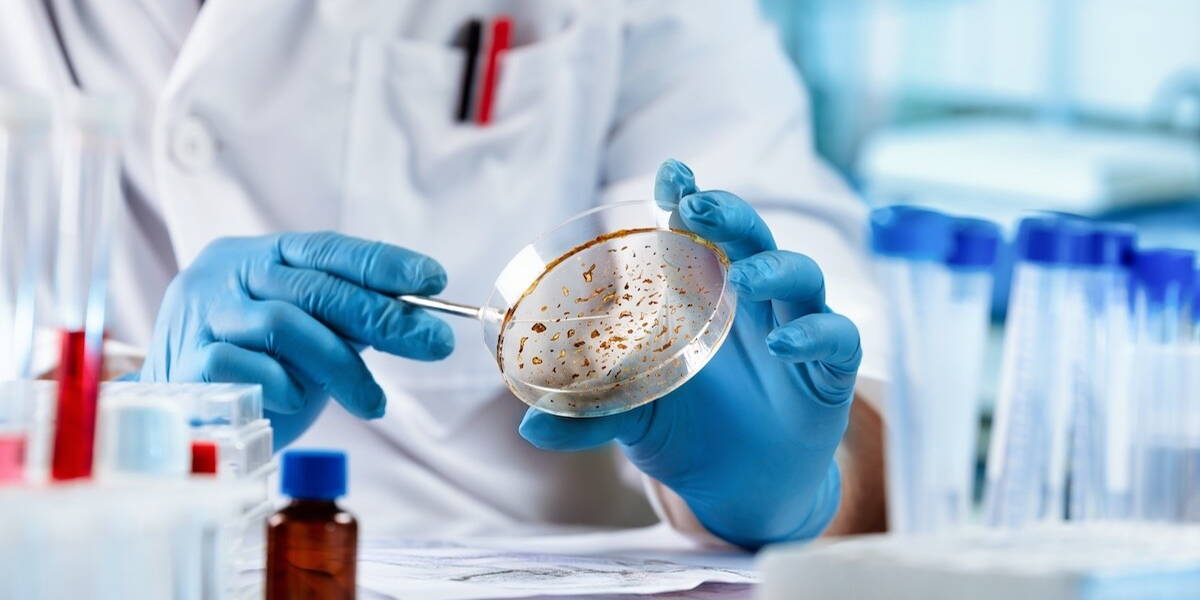

A new AI system developed by ARUP Laboratories detects intestinal parasites in stool samples faster and more accurately than experienced microscopists. The technology, based on a deep learning model, could fundamentally change the way laboratories worldwide diagnose parasitic infections.
Identifying parasites has traditionally been a time-consuming task, requiring experts to search for cysts, eggs or larvae under a microscope. The new AI solution, a so-called convolutional neural network (CNN), takes over most of this work and delivers higher sensitivity and accuracy. ‘Our validation studies show that the AI algorithm has better clinical sensitivity than the human observer,’ said Dr Blaine Mathison, technical director of parasitology at ARUP and lead author of the study, published in the Journal of Clinical Microbiology.
Training on thousands of samples worldwide
The AI was trained on more than 4,000 parasite-positive samples from laboratories in the US, Europe, Africa and Asia. The dataset included 27 parasite species, including rare variants such as Schistosoma japonicum and Paracapillaria philippinensis.
The results speak for themselves: the agreement between AI and human assessment was 98.6%, and the AI identified 169 additional organisms that had been missed during manual inspection. Even with diluted samples, the system detected more parasites than experienced laboratory technicians. This is an important step towards early diagnosis and more effective treatment. The research was published in The Journal of Clinical Microbiology.
From innovation to clinical practice
ARUP is one of the pioneers in the application of AI in clinical microbiology. As early as 2019, the laboratory was using artificial intelligence to analyse ova and parasite tests. Since March 2025, it has been the first clinical institution in the world to use AI for the entire testing process, including wet mount analysis.
The results are immediately noticeable in practice. When ARUP received a record number of samples in August, AI support enabled the laboratory to meet demand without compromising on quality or speed. ‘AI is only as good as the people who develop it,’ emphasises Adam Barker, chief operations officer at ARUP. ‘Thanks to our experts, we now have a solution that not only makes the laboratory more efficient, but also benefits patients worldwide.’
The future of diagnostics
The collaboration between ARUP and technology company Techcyte shows how artificial intelligence is increasingly becoming part of diagnostic testing. In addition to parasitology, ARUP now applies AI to Pap tests and is working on new applications for laboratory optimisation and diagnostic accuracy.
With this breakthrough, AI is once again taking a major step towards faster, more reliable and more accessible diagnostics, enabling patients to receive the right treatment more quickly.
AI diagnostics
Recently Researchers from the Icahn School of Medicine at Mount Sinai developed MARQO, an advanced AI platform that automates the analysis of cancer tissue images. MARQO processes immunohistochemical (IHC) and immunofluorescence (IF) images in minutes, detecting cell types, biomarkers, and spatial patterns across entire slides with high precision.
Unlike manual assessments, the system improves speed, scalability, and reproducibility using standard lab equipment. Compatible with existing imaging methods, MARQO allows better data comparison between studies. The tool promises faster biomarker discovery, improved treatment predictions, and greater personalisation of cancer care, bridging AI innovation and pathology expertise.